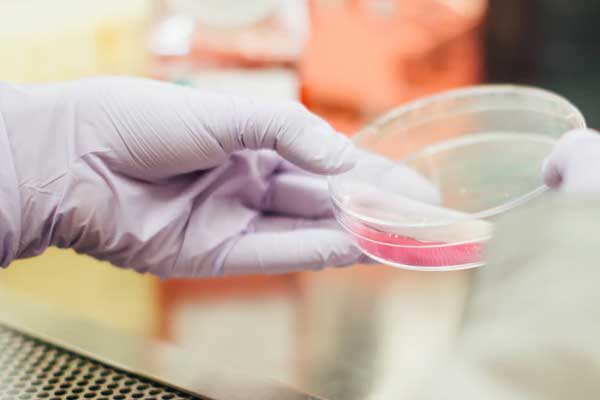

报考研究生建议大家选择通辽考研辅导寄宿班学习,该机构办学时间久、师资力量雄厚、通过率高、口碑很好是考生们值得信赖的学习机构。随着社会竞争越来越大,很多人不满足现在的学历与工作,想通过考研来提升自己的学历,找到自己喜欢的工作,纷纷选择加入考研大军,想要在大军中脱颖而出,并不是一件容易的事情,参加考研辅导寄宿班报名学习是考生的明智之举,有专业老师为你答疑解惑,可以让你少走很多弯路,提高学习效率,顺利通过考试。
中公考研
一、通辽考研辅导寄宿班
| 课程班型 | 备考规划 | 贴心服务 |
| 全年集训 | 错因分析:收集历年模考数据,汇总错题,分析错因,助你规避易错点; 萃取经验:根据历年考题梳理分析,按照不同类型,总结相应的解题技巧 |
早训+晚练 师资在早上进行带背,晚上进行带练,巩固所学; 实战模拟 选取难度和来源同考题一致的题材,强化应试能力; 严格督学 考勤监督,上课提醒,双师陪伴式督学; 批改服务 测试批改,实战模拟批改,作文批改; 答疑指导 每天专职老师坐班答疑,及时解决考研疑难; 考前点睛 考前点睛高频题型命题点以及命题角度。 |
| 半年集训 | 基础考点精讲:知识梳理,基础加固,搭建框架,重难点明晰 | |
| 暑期集训 | 0基础搭乘快车道:复习时间充分,备考效率高、基础薄弱搭建各学科知识体系、抓重点刷必做题,搭乘加分快车道; 重要知识点,巩固衔接:构建属于自己的知识脉络、知识充分内化,吃透前期复习要点、 重点题型练习,掌握解题方法; 开启新的备考环节: 熟悉历年试题,强化解题思路、实战演练测试,检验复习效果、收集易错知识点,调整复习计划 |
|
| 秋季集训 | 夯实知识点:利用最后的时间快速梳理知识体系,以题代练,落实考试硬指标,基础扎实强化过程才不虚; 实战强化进阶:用做题检验基础,知识进阶,二次固基,层层推进,杜绝赶鸭子上架; 核心考点精讲:练习中暴露出的问题再次讲解,这次挑重点细致精讲,查缺补漏,疏通难点所在; 考前应试点睛:依照学习效果,以应试为目标,模拟演练,重点题型点睛,挖命题思路。 |
|
| 复试集训 | 综合面试辅导、英语复试辅导、专业课辅导、调剂针对指导 | |
| 考前集训 | 学习有陪伴:7天集训学习,严格督学, 充分所学; 重点有梳理:梳理串讲高频点,考前再 记一遍; 答题有技巧:传授快速识别题目,针对 性解题技巧; 复习有范围:缩小备考范围,提炼重点 内容; 效果有检测:实战教学,模拟考场,提前适应; 考前有点睛:考前点睛重要试题,复习更有方向 |
|
| MPAcc复试 | 专业课+政治(笔试),强化“硬”竞争力; 英语(口语/听力),强化“软”竞争力; 面试实战演练,强化“综合”竞争力; 目标院校定向辅导,锁定“核心”竞争力 |
二、通辽考研辅导学费一般多少钱
通辽考研辅导机构不同课程、课程班型类型,定价标准是不同的,课程班型分全年、半年、暑假、秋季、复试等培训班型,有学习需求的朋友可以根据班型咨询在线老师了解费用情况。

三、考研辅导班有用吗
考研是一场持久战,比较考验大家的自律能力。如果自制力强,能克服诱惑,抵制外界干扰,那一个人跟着网课也是能学好的。如果自制力稍差,容易被情绪牵着走,容易受外界干扰影响复习进度,那么报个班有考研老师为你指引方向、可以打开你的复习思维、有疑问或者问题随时都有答疑老师为你答疑解惑,可以少走很多弯路,也少了很多自己找资料和摸索需要花的时间和精力。所以,报班有没有用,到底要不要报班还是要根据自己的具体情况来选择。
四、通辽中公考研机构介绍
现在市场上考研机构有不少,各种各样的培训机构层出不穷,所以选择的时候一定要有辨别能力。通辽中公考研机构专注考研培训,主要为考研学子提供考研资讯及复习资料,相关院校信息库、专业目录查询、历年分数线、复试调剂技巧,学科复习指南等对考研有用的资料信息。
中公考研机构组建了专业的教研团队,凭借强大科研实力,整合行业资源,打造优质教学课程,提供课程、考勤、心理、住宿、自习、集中式管理等方面的服务,经多年的发展创新,成为了行业里认可的专业考研教育机构。
